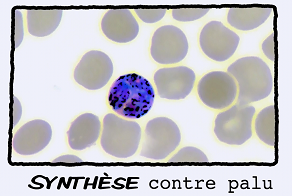

Toute la Chimie en série
Collections

Vidéos Des idées plein la Tech

Toute la collection
communication, odeurs, conscience, Claire de March, molécule odorante, récepteur olfactif, neurone, souris, agressivité, comportement, phéromone, maladies, neurodégénératives, ectopique
nano-diagnostic médical, bio-marqueurs luminescents, traçage par photoluminescence, point quantique, quantum dots